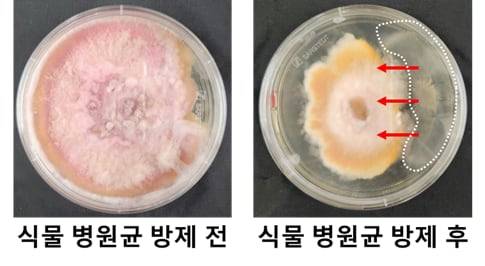
식물 병원균의 노출 상태(좌)와 치료균 캡슐 투입 후 병원균 제거 상태./인하대

버려진 멍게 껍질, 친환경 농약으로 변신
전체 맥락을 이해하기 위해서는 본문 보기를 권장합니다.
국내 연구진이 버려지는 멍게 껍질을 활용해 친환경 농약을 개발하는 데 성공했다.
이 농약은 땅속에서 자연 분해되며, 비가 오거나 토양이 알칼리성일 때 병을 막는 유익균을 스스로 방출한다.
인하대는 양윤정 생명공학과 교수 연구팀이 멍게 껍질을 활용한 친환경 생물농약 캡슐을 개발했다고 14일 밝혔다.
기존 생물농약은 환경 변화에 따라 효과가 쉽게 줄어드는 한계가 있었지만, 이번에 개발한 캡슐은 땅속 환경에 맞춰 유익균을 안정적으로 전달하도록 설계됐다.
이 글자크기로 변경됩니다.
(예시) 가장 빠른 뉴스가 있고 다양한 정보, 쌍방향 소통이 숨쉬는 다음뉴스를 만나보세요. 다음뉴스는 국내외 주요이슈와 실시간 속보, 문화생활 및 다양한 분야의 뉴스를 입체적으로 전달하고 있습니다.
땅속서 유익균 방출하는 농약 캡슐 개발


국내 연구진이 버려지는 멍게 껍질을 활용해 친환경 농약을 개발하는 데 성공했다. 이 농약은 땅속에서 자연 분해되며, 비가 오거나 토양이 알칼리성일 때 병을 막는 유익균을 스스로 방출한다.
인하대는 양윤정 생명공학과 교수 연구팀이 멍게 껍질을 활용한 친환경 생물농약 캡슐을 개발했다고 14일 밝혔다. 이번 연구 성과는 국제학술지인 ‘바이오고분자학(Biomacromolecules)’에 실렸다.
최근 화학 비료와 농약의 과도한 사용으로 환경이 오염되고, 다양한 생물이 살아가기 어려워졌다. 일부 세균이나 곰팡이는 약에 잘 듣지 않는 내성이 생겨, 기존 농약만으로는 병해충을 막기 힘든 경우가 많다.
연구팀은 이런 문제를 해결하기 위해 이번 연구를 진행했다. 기존 생물농약은 환경 변화에 따라 효과가 쉽게 줄어드는 한계가 있었지만, 이번에 개발한 캡슐은 땅속 환경에 맞춰 유익균을 안정적으로 전달하도록 설계됐다.
캡슐은 사람들이 먹지 않는 멍게 껍질 속 셀룰로오스라는 식물성 섬유질로 만들어졌다. 이 성분은 자연 분해가 가능해 환경에 부담을 주지 않는다. 병해충은 주로 알칼리성 토양에서 잘 자라고, 비가 온 뒤 빠르게 퍼진다는 점에 착안해, 캡슐이 수분과 토양 성질에 반응해 내용물을 방출하도록 했다.
캡슐 안에는 병을 막는 유익균이 들어 있다. 땅이 알칼리성이 되고 물이 스며들면 캡슐이 터지면서 균이 뿌리와 주변 토양으로 퍼져 병해충을 억제한다. 캡슐 생산 공정에는 건국대 이상현 교수팀이 개발한 기술이 적용됐다.
양윤정 교수는 “이번 연구는 버려지는 해양 부산물을 가치 있는 농약 소재로 바꾼 사례로, 친환경 농업과 자원 순환에 도움이 될 것”이라고 말했다.

참고 자료
Biomacromolecules(2025), DOI: https://doi.org/10.1021/acs.biomac.5c00340
- Copyright ⓒ 조선비즈 & Chosun.com -
Copyright © 조선비즈. 무단전재 및 재배포 금지.
- [비즈톡톡] ‘하GPT’ 이탈한 국가 AI 정책… “AI, 핵심 국정 과제 맞나” 의문
- ‘병뚜껑 파편·곰팡이' 백신 논란…정은경, 경찰 수사 속 의료개편·주사기 수급 불안에 책임론
- [단독] 폐비닐에서 나프타 뽑아낸다는 기후부 “추출량 산출은 어려워”
- 사체 피부로 만든 미용 주사 논란에…엘앤씨바이오 “심각한 부작용 없다”
- 中 보복에 日 하늘길 비상… 日 항공사 中 노선 ‘반토막’
- ‘역대급 성과급’ SK하이닉스 직원들, 세금 뗀 실수령액은 얼마
- 평택 화양지구, 4450가구 입주했는데 상가 하나 없는 ‘반쪽 신도시’
- “팔고 싶어도 못 팔아”… 2분기에도 폭주하는 D램 수요, HBM에 발 묶인 삼성전자·SK하이닉스
- 실손보험 추천 요구에 “모릅니다”… 속 터지는 보험사 AI 상담원
- 눈높이 교육이라더니, 대주주 눈높이만 맞춘 대교... 오너 배당 위해 자사주 처분